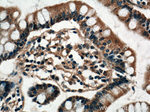
VPS39 Antibody in Immunohistochemistry (Paraffin) (IHC (P))

Search
Proteintech
VPS39 Polyclonal Antibody
{{$productOrderCtrl.translations['antibody.pdp.commerceCard.promotion.promotions']}}
{{$productOrderCtrl.translations['antibody.pdp.commerceCard.promotion.viewpromo']}}
{{$productOrderCtrl.translations['antibody.pdp.commerceCard.promotion.promocode']}}: {{promo.promoCode}} {{promo.promoTitle}} {{promo.promoDescription}}. {{$productOrderCtrl.translations['antibody.pdp.commerceCard.promotion.learnmore']}}
产品信息
16219-1-AP
种属反应
已发表种属
宿主/亚型
分类
类型
抗原
偶联物
形式
浓度
规格
纯化类型
保存液
内含物
保存条件
运输条件
产品详细信息
Immunogen sequence: ERTVQYLQH LGTENLHLIF SYSVWVLRDF PEDGLKIFTE DLPEVESLPR DRVLGFLIEN FKGLAIPYLE HIIHVWEETG SRFHNCLIQL YCEKVQGLMK EYLLSFPAGK TPVPAGEEEG ELGEYRQKLL MFLEISSYYD PGRLICDFPF DGLLEERALL LGRMGKHEQA LFIYVHILKD TRMAEEYCHK HYDRNKDGNK DVYLSLLRMY LSPPSIHCLG PIKLELLEPK ANLQAALQVL ELHHSKLDTT KALNLLPANT QINDIRIFLE KVLEENAQKK RFNQVLKNLL HAEFLRVQEE RILHQQVKCI ITEEKVCMVC KKKIGNSAFA RYPNGVVVHY FCSKEVNPAD T (537-886 aa encoded by BC015817)
靶标信息
VPS39 is the mammalian homolog of the yeast vacuolar protein VAM6, that in mammals, promotes lysosome clustering and fusion in vivo. VPS39 is also thought to modulate the TGF-beta response by coupling the TGF-beta receptor complex to the Smad pathway. Similar to the related protein TRAP1, the VPS39 protein is essential for early embryonic development, with mice lacking VPS39 dying at or before E6. 5.
仅用于科研。不用于诊断过程。未经明确授权不得转售。
生物信息学
蛋白别名: hVam6p; OTTMUSP00000023341; OTTMUSP00000023350; PI3K type 3; TRAP1-like protein; unnamed protein product; vacuolar protein sorting 39 homolog; Vam6/Vps39-like protein; VPS39, HOPS complex subunit
基因别名: A230065P22Rik; AW743070; hVam6p; KIAA0770; mVam6; Pldn; TLP; VAM6; Vam6P; VPS39
UniProt ID: (Human) Q96JC1, (Mouse) Q8R5L3
Entrez Gene ID: (Human) 23339, (Mouse) 269338